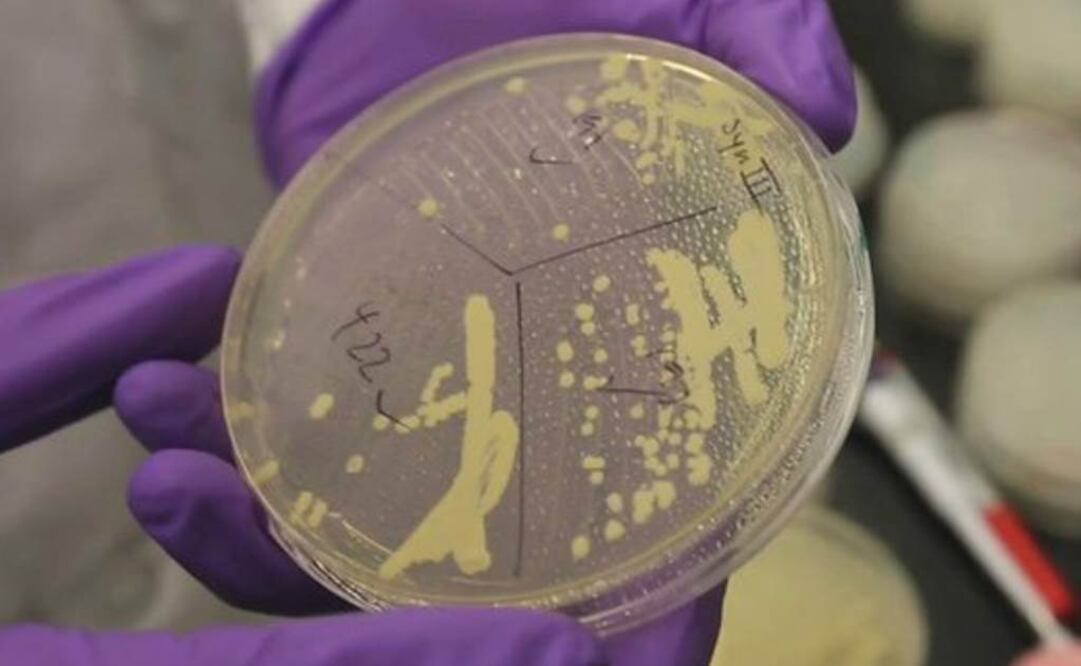
Tendrían mayor acceso a la población. Foto: Archivo

[Publicidad]
Científicos de la Universidad de Stanford han descubierto un método para alterar genéticamente la levadura y producir con más rapidez los ingredientes activos de los analgésicos opiáceos, informó este jueves la revista Science.
El descubrimiento reducirá el tiempo de producción de los analgésicos de un año a tres o cinco días, lo que permitirá desarrollar a menor coste un amplio elenco de los ingredientes de las medicinas producidas a base de plantas, según destaca el estudio divulgado por la publicación científica.
Después de una década de trabajo, los científicos de la universidad californiana descubrieron cómo reprogramar la maquinaria genética de la levadura de pan para que las células de rápido crecimiento de esta sustancia conviertan el azúcar en hidrocodona, un opioide derivado de la codeína que se utiliza como analgésico.
Según los investigadores de Stanford, la hidrocodona puede tardar más de un año en ser cultivada en las granjas de Australia, Europa y otros lugares que tienen licencia para obtener amapolas de opio, a partir de las cuales se produce esta sustancia.
Una vez cosechada una cantidad suficiente para producir un lote, el material vegetal es enviado a fábricas farmacéuticas en Estados Unidos, donde las moléculas se extraen y refinan para que puedan ser utilizadas como medicamentos.
"Cuando empezamos a trabajar hace una década, muchos expertos pensaron que sería imposible diseñar levaduras que reemplazaran el proceso de producción que comienza en estas granjas y llega a las fábricas", destacó Christina Smolke, profesora asociada de Bioingeniería en Stanford y autora principal del estudio.
"Ésto es sólo el comienzo (...). Las técnicas que hemos desarrollado para los analgésicos opioides pueden adaptarse para producir muchos compuestos derivados de plantas destinados a combatir el cáncer, enfermedades infecciosas o enfermedades crónicas como la hipertensión arterial y la artritis", destacó Smolke.
A pesar del descubrimiento, en su artículo de Science, los científicos reconocen que una aceleración de la producción de los analgésicos opioides y un mayor acceso a la población de estos fármacos podría incrementar los abusos.
"Necesitamos aseguraros de que la producción de medicamentos de base biológica se hace de la forma más responsable posible", reconoció la científica, que consideró esencial un desarrollo equilibrado de los analgésicos para evitar abusos y facilitar el acceso a aquellos que los necesitan.
En este sentido, Smolke destacó que en Estados Unidos habría que tratar de evitar el mal uso de los analgésicos opioides, que están ampliamente disponibles y que pueden llegar a ser fuertemente adictivos si se toman de forma descontrolada.
Sin embargo, 5 mil 500 millones de personas (el 83 % de la población mundial) vive en países con un bajo o inexistente acceso a los medicamentos destinados a aliviar el dolor, según datos de la Organización Mundial de la Salud (OMS).
kal
[Publicidad]
Más información

Universal Deportes
Figuras internacionales de LMB superan a México en Juego de Estrellas 2026; Robinson Canó, el MVP

Estados
Félix Salgado queda fuera de la encuesta en Guerrero; sostiene que Morena no puede estar sobre la Constitución

Estados
Desaparecen dos trabajadores de la CFE en Hidalgo; hallan abandonada su camioneta sin logotipos

Metrópoli
Instalan gigante futbolero en Utopía Meyehualco; vecinos de Iztapalapa se reúnen para ver el Mundial